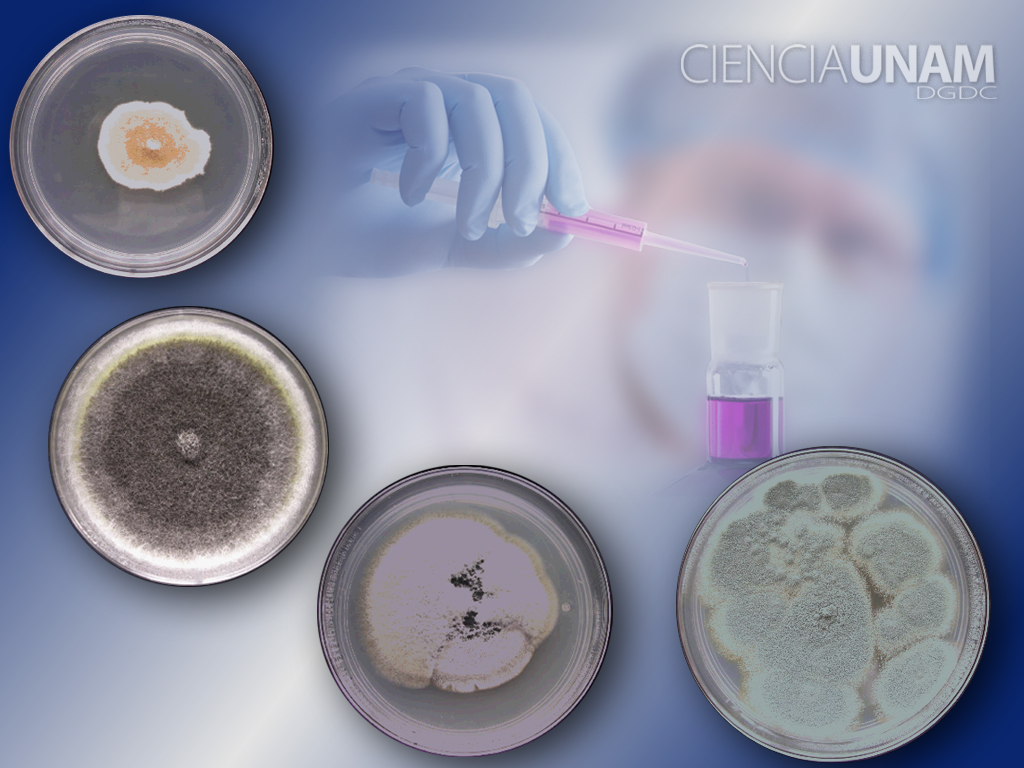

- Inicio
- ⟩
- Ambiente y Naturaleza
- ⟩
- Hongos micorrizógenos, clave para el desarrollo de la agricultura orgánica
Hongos micorrizógenos, clave para el desarrollo de la agricultura orgánica

Al menos 25 estados de la República mexicana producen alimentos orgánicos. Foto: Bárbara Castrejón Gómez.
01-10-2012
Por Sofía Flores Fuentes, DGDC-UNAM
El estudio de las especies de hongos micorrizógenos que actúan como biofertilizantes ayudaría a extender los métodos de la agricultura orgánica en México, lo que constituiría una alternativa para aumentar la producción de alimentos básicos del mexicano como el maíz, el jitomate y el trigo, afirmó Arcadio Monroy Ata, investigador de la Facultad de Estudios Superiores (FES) Zaragoza de la UNAM.
El especialista reportó que de las 300 especies registradas en el mundo, 70 están presentes en suelos del territorio nacional; sin embargo, la mayoría de ellas sólo está inventariada y no se sabe cuál es su papel específico en el ecosistema, a pesar de los beneficios que aportan a la agricultura sustentable.
Los hongos micorrizógenos actúan como fertilizantes naturales sin las repercusiones en el suelo y la salud humana que tienen los fertilizantes químicos usados en la agricultura convencional. El doctor Monroy comentó que los agricultores orgánicos hacen uso de algunas especies de estos microorganismos, a partir de las cuales se elaboran biofertilizantes comerciales, pero otras todavía no han sido estudiadas lo suficiente como para emplearlas en los cultivos.
Arcadio Monroy explicó que la utilización de los hongos micorrizógenos en la agricultura orgánica se debe a su función compatible con las condiciones naturales del ecosistema. Recordó que este tipo de agricultura depende de insumos naturales como abonos orgánicos, control biológico de plagas y biofertilizantes, además se basa en técnicas sustentables como el policultivo y la rotación de cultivo, a fin de evitar el uso de la maquinaria convencional que daña la integridad del suelo.
A nivel mundial, se reconoce el potencial de la agricultura orgánica como alternativa para erradicar los problemas ecológicos del cultivo convencional, como la sobreexplotación y la degradación del suelo. En México, Chiapas es pionero en la producción de café orgánico.
De acuerdo con el biólogo de la FES Zaragoza, alrededor de 25 estados de la República mexicana generan productos orgánicos, de los cuales el 80% se destina a la exportación. “En mi opinión, los hongos micorrizógenos son clave para el desarrollo de la agricultura orgánica”, declaró el investigador.
@#Fertilizantes naturales#@
Los hongos micorrizógenos arbusculares, o micorrizas, son asociaciones de mutuo beneficio entre los hongos y las raíces de las plantas. Por un lado, el hongo recibe azúcares de la planta y, por otro, este microorganismo metaboliza el nitrógeno de la atmósfera para dárselo a la planta como alimento.
De todas las plantas del planeta, el 95% tiene asociación con las micorrizas. Dicha relación es parte de la dinámica natural del ecosistema, de la que depende el crecimiento de la planta y la fertilidad del suelo.
El estudio de la función de los hongos micorrizógenos permite conocer aspectos como su metabolismo, las sustancias que producen, sus necesidades alimenticias y ambientales y la relación que establecen con cada planta. Mediante la reproducción en laboratorio es posible obtener una gran cantidad de este material biológico para aplicaciones en la agricultura.
El investigador Monroy Ata ha realizado evaluaciones del desempeño de estos microorganismos como sustitutos de los fertilizantes químicos en cultivos comerciales de lechuga y verdolagas, cuyo resultado muestra un rendimiento óptimo. A la par, trabaja en ambientes semiáridos del Valle del Mezquital, Hidalgo, en donde caracteriza hongos específicos de cactáceas, como el nopal o la biznaga.
Describió que el método de reproducción de las especies en el laboratorio consiste en cultivar, en suelo estéril y arenoso, las muestras de los hongos recolectadas en campo junto con plantas que se asocian fácilmente a ellos, como el jitomate. Días después, la planta se seca y se corta; entonces el hongo deja de recibir azúcares y comienza a formar esporas en respuesta al estrés alimentario.
Con este método se puede partir de una muestra muy pequeña de esporas, que da origen a cientos de millones de hongos micorrizógenos, potencialmente útiles en la agricultura orgánica o en el rescate de ecosistemas deteriorados.
“En el Valle del Mezquital, la planta dominante era el mezquite, pero actualmente se ha reducido el número de ejemplares por su uso. Lo que hacemos es recolectar semillas de mezquite y las sembramos junto con los hongos para reintroducirlos en campo. La supervivencia de la planta con micorriza se duplica”, reportó el biólogo de la UNAM.
Para concluir, señaló que cada hongo y especie vegetal establecen un vínculo específico, por lo que llamó a incrementar el estudio de la relación entre cada especie de micorriza y planta de interés alimentario como el maíz, el jitomate y el trigo, con el fin de elaborar nuevos biofertilizantes destinados a estos cultivos.
Publicaciones relacionadas

Huertos urbanos apoyan la agricultura familiar

La milpa, tradición milenaria de agricultura familiar
Hongos contra el cáncer















